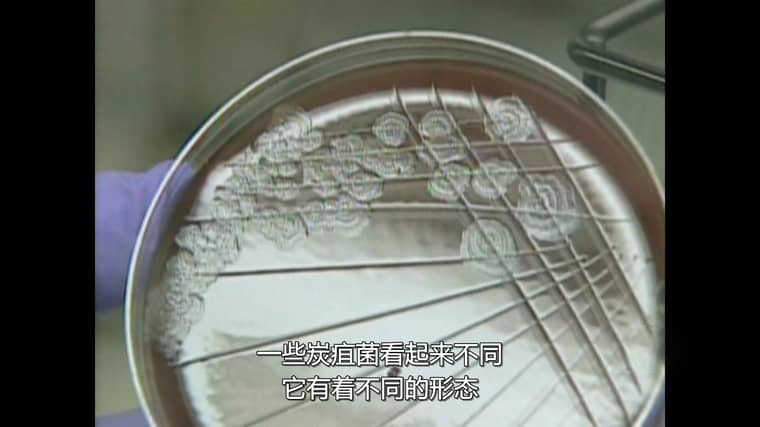

《致命邮件:2001 美国炭疽攻击事件》:揭开黑暗历史的伤痛面纱
2001年,对于美国而言,是多事之秋。“9·11”恐怖袭击的阴霾尚未完全消散,一场更为隐蔽且致命的危机又悄然降临——炭疽攻击事件。BBC工作室精心打造的纪录片《致命邮件:2001美国炭疽攻击事件 The Anthrax Attacks 2022》,宛如一把手术刀,精准地剖析了这起震惊世界的事件,带我们走进那段充满恐惧与伤痛的历史。

这部纪录片由奥斯卡提名导演丹克劳斯操刀,他以独特的视角和精湛的叙事手法,为我们呈现了这起事件的全貌。这不仅是一个简单的事件记录,更是执法史上规模最大、最复杂的联邦调查局调查之一的深度揭秘。整个调查过程犹如一场漫长而艰难的马拉松,充满了曲折与挑战。
纪录片巧妙地结合了基于电子邮件和联邦调查局现场笔记的采访以及脚本重演。通过采访调查人员,我们得以了解到他们在调查过程中所面临的重重困难和压力。他们不放过任何一个细微的线索,在浩如烟海的信息中抽丝剥茧,试图找出幕后黑手。每一个线索的发现都可能是一次突破,但也可能是一个陷阱,将他们引入更深的谜团之中。

而脚本重演则让我们仿佛置身于事件的现场,亲身感受那紧张而恐怖的氛围。一封封看似普通的邮件,却隐藏着致命的炭疽孢子。当收件人打开邮件的那一刻,无形的杀手便悄然释放,迅速在空气中传播。那些感染炭疽的人,在毫无防备的情况下,身体逐渐被病魔侵蚀,痛苦不堪。
纪录片中还分享了来自幸存者和感染者家属的故事,这些故事令人震惊和心碎。幸存者们在与死神的搏斗中,经历了身体和心理的双重折磨。他们回忆起感染时的症状,那种呼吸困难、高烧不退的痛苦仿佛就在眼前。而感染者家属们,则承受着失去亲人的巨大悲痛。他们眼睁睁地看着亲人在病痛中挣扎,却无能为力。一位家属哭诉道:“我从未想过,一封邮件会夺走我最爱的人的生命,这就像一场噩梦,我至今都无法醒来。”

这起炭疽攻击事件不仅仅是对美国民众生命安全的威胁,更是对整个社会秩序和信任的沉重打击。人们开始对日常的邮件往来产生恐惧,每一封信都可能成为死亡的邀请函。政府部门也陷入了巨大的压力之中,他们需要迅速采取措施,控制疫情的蔓延,同时还要安抚民众的恐慌情绪。
随着调查的深入,一些线索逐渐浮出水面,但真相却依然扑朔迷离。究竟是谁策划了这起恐怖的袭击?他们的目的又是什么?这些问题如同乌云一般,笼罩在人们的心头。纪录片并没有直接给出答案,而是引导我们去思考和探索,让我们明白,在面对这样的危机时,我们需要保持警惕,共同努力,才能守护我们的安全和未来。

《致命邮件:2001美国炭疽攻击事件 The Anthrax Attacks 2022》是一部具有深刻社会意义的纪录片。它让我们铭记历史,珍惜和平,同时也提醒我们,在这个充满不确定性的世界里,我们需要时刻做好应对各种危机的准备。
